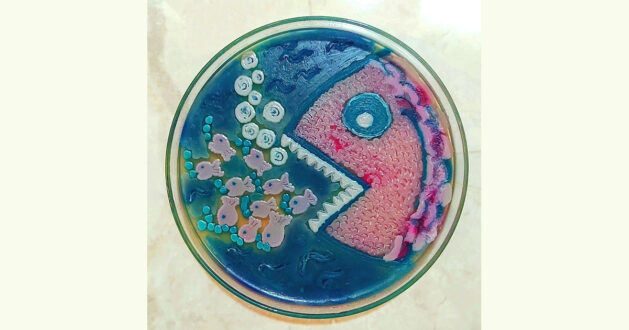

“Candida auris: Emerging into The World of Fungi” adlı eseri, 33. Avrupa Klinik Mikrobiyoloji ve Enfeksiyon Hastalıkları Kongresinde #ECCMID2023 Sanat Galerisi, Agar Art dalında yayınlanmaya ve ödüle layık bulunan meslektaşımız Ilvana Küçükkaya’yı tebrik ederiz.
We have another Agar Art winner from the #ECCMID2023 Art Gallery! Congrats to Ilvana Küçükkaya (Turkey) who won with her piece "Candida auris: Emerging into The World of Fungi" depicting C auris as the predator we know it is! We hope you enjoy your #ECCMID surprise box #ECCMIDart pic.twitter.com/kTiYpHXZNt
— ESCMID (@ESCMID) January 23, 2023

